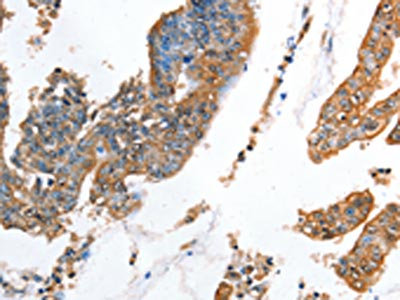

AKR1D1 Antibody
-
中文名稱:AKR1D1兔多克隆抗體
-
貨號:CSB-PA217516
-
規(guī)格:¥1100
-
圖片:
-
The image on the left is immunohistochemistry of paraffin-embedded Human colon cancer tissue using CSB-PA217516(AKR1D1 Antibody) at dilution 1/35, on the right is treated with fusion protein. (Original magnification: ×200)
-
The image on the left is immunohistochemistry of paraffin-embedded Human gastric cancer tissue using CSB-PA217516(AKR1D1 Antibody) at dilution 1/35, on the right is treated with fusion protein. (Original magnification: ×200)
-
Gel: 8%SDS-PAGE, Lysate: 80 μg, Lane: Human liver cancer tissue, Primary antibody: CSB-PA217516(AKR1D1 Antibody) at dilution 1/650, Secondary antibody: Goat anti rabbit IgG at 1/8000 dilution, Exposure time: 1 minute
-
-
其他:
產品詳情
-
Uniprot No.:
-
基因名:
-
別名:3-oxo-5-beta-steroid 4-dehydrogenase antibody; 3o5bred antibody; AK1D1_HUMAN antibody; AKR1D1 antibody; aldo keto reductase family 1 member D1 (delta 4 3 ketosteroid 5 beta reductase) antibody; Aldo keto reductase family 1 member D1 antibody; Aldo-keto reductase family 1 member D1 antibody; CBAS2 antibody; Delta(4) 3 ketosteroid 5 beta reductase antibody; Delta(4) 3 oxosteroid 5 beta reductase antibody; Delta(4)-3-ketosteroid 5-beta-reductase antibody; Delta(4)-3-oxosteroid 5-beta-reductase antibody; SRD5B1 antibody; steroid 5 beta reductase beta polypeptide 1 (3 oxo 5 beta steroid delta 4 dehydrogenase beta 1) antibody; steroid 5 beta reductase antibody
-
宿主:Rabbit
-
反應種屬:Human,Mouse,Rat
-
免疫原:Fusion protein of Human AKR1D1
-
免疫原種屬:Homo sapiens (Human)
-
標記方式:Non-conjugated
-
抗體亞型:IgG
-
純化方式:Antigen affinity purification
-
濃度:It differs from different batches. Please contact us to confirm it.
-
保存緩沖液:-20°C, pH7.4 PBS, 0.05% NaN3, 40% Glycerol
-
產品提供形式:Liquid
-
應用范圍:ELISA,WB,IHC
-
推薦稀釋比:
Application Recommended Dilution ELISA 1:2000-1:5000 WB 1:500-1:2000 IHC 1:50-1:200 -
Protocols:
-
儲存條件:Upon receipt, store at -20°C or -80°C. Avoid repeated freeze.
-
貨期:Basically, we can dispatch the products out in 1-3 working days after receiving your orders. Delivery time maybe differs from different purchasing way or location, please kindly consult your local distributors for specific delivery time.
-
用途:For Research Use Only. Not for use in diagnostic or therapeutic procedures.
相關產品
靶點詳情
-
功能:Catalyzes the stereospecific NADPH-dependent reduction of the C4-C5 double bond of bile acid intermediates and steroid hormones carrying a delta(4)-3-one structure to yield an A/B cis-ring junction. This cis-configuration is crucial for bile acid biosynthesis and plays important roles in steroid metabolism. Capable of reducing a broad range of delta-(4)-3-ketosteroids from C18 (such as, 17beta-hydroxyestr-4-en-3-one) to C27 (such as, 7alpha-hydroxycholest-4-en-3-one).
-
基因功能參考文獻:
- infant proved to be a compound heterozygote of the AKR1D1 variants c.579+2delT and c.853C>T(p.Q285X), two novel mutations originated from his mother and father, respectively PMID: 28697823
- Impaired NADPH binding and hydride transfer is the molecular basis for bile acid deficiency in patients with the P133R mutation in AKR1D1. PMID: 26418565
- When different steroid substrates were used in single turnover experiments with AKR1D1. PMID: 25500266
- AKR1D1 generates all 5beta-dihydrosteroids in the C19-C27 steroid series. PMID: 24513054
- Despite having high kchem values with steroid hormones, the kinetic control of AKR1D1 is consistent with the enzyme catalysing the slowest step in the catabolic sequence of steroid hormone transformation in the liver. PMID: 24894951
- Studies indicate that mutations in aldo-keto reductase family 1 (AKR1) enzymes AKR1C1 and AKR1C4 are responsible for sexual development dysgenesis and mutations in AKR1D1 are causative in bile-acid deficiency. PMID: 24189185
- Novel homozygous frameshift mutations in the AKR1D1 gene and in the SKIV2L gene were found in a family with severe infantile liver disease. PMID: 23679950
- Consistent with AKR1D1's putative role as a driver of the P450 subnetwork, the AKR1D1 3'-UTR SNP was significantly associated with increased hepatic mRNA expression of multiple P450s PMID: 23704699
- These studies show how a single point mutation in AKR1D1 can introduce HSD activity with unexpected configurational and stereochemical preference. PMID: 22437839
- all five mutations identified in patients with functional bile acid deficiency strongly affected AKR1D1 enzyme functionality and therefore may be causal for this disease PMID: 21185810
- determined the substrate specificity of homogeneous human recombinant AKR1D1 using C18, C19, C21, and C27 Delta(4)-ketosteroids and assessed the pH-rate dependence of the enzyme. PMID: 21255593
- analysis of disease-related 5beta-reductase (AKR1D1) mutations reveals their potential to cause bile acid deficiency PMID: 20522910
- In placenta and myometrium, relative expression decreased significantly in association with labour, by about two-fold and 10-fold, respectively. These data are consistent with a possible role for 5betaDHP in the onset of spontaneous human labour. PMID: 16123077
- analysis of human liver Delta4-3-ketosteroid 5beta-reductase (AKR1D1) crystal structure and implications for substrate binding and catalysis PMID: 18407998
- The structures of an AKR1D1-NADP(+) binary complex, and AKR1D1-NADP(+)-cortisone, AKR1D1-NADP(+)-progesterone and AKR1D1-NADP(+)-testosterone ternary complexes at high resolutions, is reported. PMID: 18848863
- Structure determination of human AKR1C4 and homology modelling of AKR1D1 followed by docking experiments were used to explore active site geometries. PMID: 19013211
- Delta4-3-ketosteroid 5beta-reductase (AKR1D1) has an alternative binding site responsible for substrate inhibition PMID: 19075558
- SRD5B1 gene analysis needed for the accurate diagnosis of primary 3-oxo-Delta4-steroid 5beta-reductase deficiency. PMID: 19175828
顯示更多
收起更多
-
相關疾病:Congenital bile acid synthesis defect 2 (CBAS2)
-
亞細胞定位:Cytoplasm.
-
蛋白家族:Aldo/keto reductase family
-
組織特異性:Highly expressed in liver. Expressed in testis and weakly in colon.
-
數(shù)據(jù)庫鏈接:
Most popular with customers
-
-
Phospho-YAP1 (S127) Recombinant Monoclonal Antibody
Applications: ELISA, WB, IHC
Species Reactivity: Human
-
-
-
-
-
-